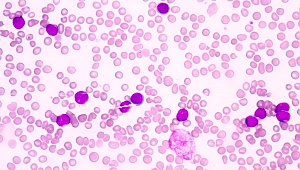
Akut lösemide her zaman umut var

Gebze Yenigün Haberleri
Gebze Yenigün


01 Eylül 2019 - 11:54
"En temel kavram barıştır" 
01 Eylül 2019 - 11:47
Bağlantı yolları için çalışmalar sürüyor 
01 Eylül 2019 - 11:37
Olası can kaybının önüne geçildi 
01 Eylül 2019 - 11:32
Bel ağrılarını ciddiye alın
01 Eylül 2019 - 11:25
Akut lösemide her zaman umut var 
01 Eylül 2019 - 11:20
Omuzlarınız eşit değilse dikkat! 
01 Eylül 2019 - 10:13
Otel konforunda ‘Barınma Merkezi’ 
01 Eylül 2019 - 10:03
Büyükgöz dert dinliyor 
01 Eylül 2019 - 09:40
Gebze zaferi Işın Karaca ile kutladı 
31 Ağustos 2019 - 12:40
Halit Yaşar'ın acı günü 
31 Ağustos 2019 - 10:33
Işın Karaca'dan geriye kalan 
30 Ağustos 2019 - 23:03
GMK'dan zafer konvoyu